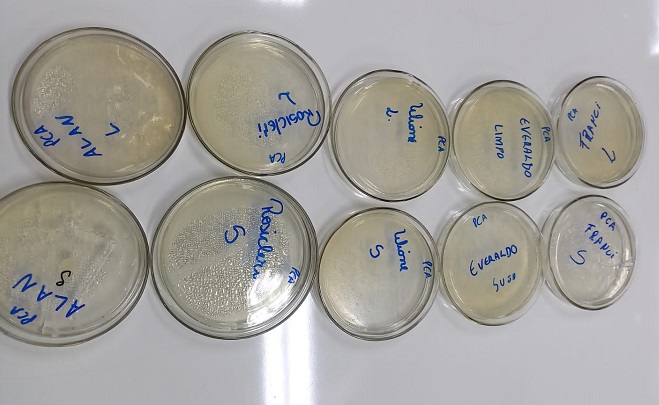
n 0056 1

Nessa semana, a FAHOR encerrou mais uma formação profissional em Boas Práticas na Manipulação de Alimentos, tendo as professoras Cláudia Verdum Viegas e Ana Paula Cecatto.
Foram 30 participantes que aprenderam sobre: microbiologia dos alimentos, contaminantes alimentares; doenças transmitidas por alimentos; pré-preparo, preparo, conservação; destino das sobras; Controle da qualidade da água de abastecimento; Controle integrado de pragas; Controle da saúde dos manipuladores; higiene do ambiente, utensílios e equipamentos; Higiene pessoal e comportamento no trabalho; Contaminação cruzada; alimentos crus e cozidos; Manejo de resíduos (lixo); Regras para visitantes e documentação da qualidade (Manual e POPs).
Além do compartilhamento de informações técnicas o Curso é bastante prático, com realização de análises microbiológicas, para melhor compreensão dos riscos de contaminação e da importância de manter processos e padrões de higiene, para obter a qualidade na manipulação de alimentos e bebidas.
Na FAHOR, o Curso de Boas Práticas é reconhecido pela Vigilância Sanitária sendo que o conteúdo, carga horária e certificação estão em conformidade com a Portaria n° 78/2009.
